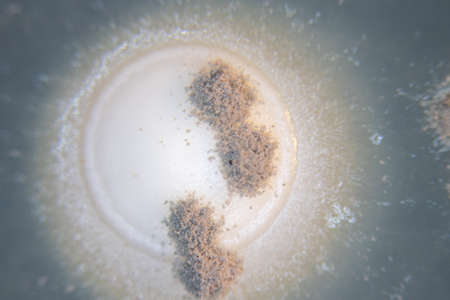
Backgrounds of Characteristics  of Bacteria and Fungi  for education in Microbiology laboratory.の写真素材

写真素材 - Backgrounds of Characteristics of Bacteria and Fungi for education in Microbiology laboratory.
作品情報
Backgrounds of Characteristics of Bacteria and Fungi for education in Microbiology laboratory.
- ID:187422656
- 作品種別:写真
- 作者名:sinhyu
キーワード
- actinomyces
- agar
- analysis
- background
- bacteria
- bacterial
- bacterium
- biology
- biotechnology
- cells
- characteristic
- colonies
- colony
- culture
- danger
- disease
- dish
- education
- environment
- experimental
- food
- fungi
- germs
- gram negative
- growth
- health
- hygiene
- isolated
- lab
- laboratory
- medical
- medicine
- microbial
- microbiology
- microorganism
- mold
- organism
- pathogen
- petri
- plate
- research
- risk
- sample
- science
- scientific
- soil samples
- species
- texture
- white
- yeast
類似作品
Backgrounds of ...
Fungi culture o...
Mould aka mold ...
Abstract ink te...
macro of mold r...
Germs Bacteria ...
cherry jelly wi...
Mold growing ra...
Backgrounds of ...
Mold close-up m...
Characteristics...
Backgrounds of ...
Backgrounds of ...
Close-up of a g...
Penicillium, as...
Backgrounds of ...
Fungi culture o...
Mold growing on...
microbiological...
Green mold on f...
Mold in a can o...
Penicillium bra...
Penicillium, as...
Characteristics...
Dry old stump i...
Raindrop Fungus
tea mold in a c...
Backgrounds of ...
Flora, branding...
cherry jam is c...
moldy bread clo...
Mushroom cultiv...
mold on juice, ...
Yellow maritime...
Backgrounds of ...
a mold colony o...
Bacterial and m...
Luxury Larimar ...
Penicillium fun...
Abstract brown ...
Texture of wall...
An element of a...
mold in orange ...
Backgrounds of ...
Multicolored mo...
Close up of nat...
Xanthoria polyc...
Cultured yeasts...
A lone mushroom...